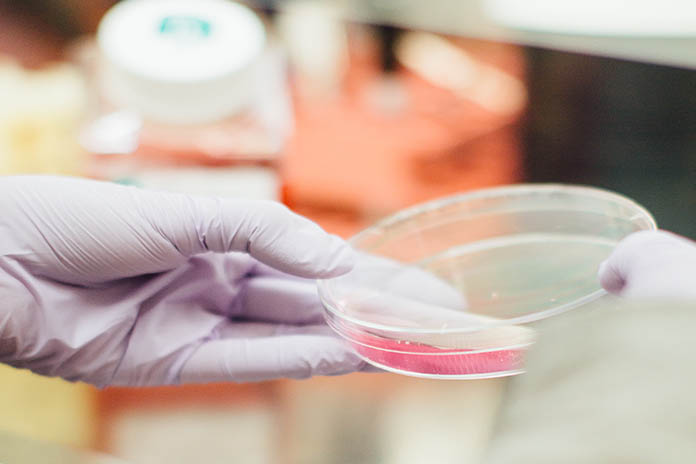

2
019年台北市十大死因出爐,慢性疾病囊括7項,每100人中約有63.0人死於慢性疾病,惡性腫瘤則續居首席,而十大死因排名順序與2018年相較,完全一致。至於十大癌症死因仍以肺癌連續34年蟬聯首席,而女性乳房癌躍身為次席。
2019年台北市民死亡人數為1萬8,024人,較上年微減0.1% (或減26人),近10年平均年增率1.9%;死亡率則為每十萬人口678.4人,較上年微增0.6%(或增3.9人),近10年平均年增率1.8%,死亡者年齡中位數為80歲,較全國77歲為高。如依世界衛生組織WHO公布2000年世界標準人口結構調整計算,標準化死亡率為每十萬人口309.9人,較上年減2.4%(或減7.7人) ,近10年則平均年降1.1%,並低於全國標準化死亡率408.2人,是全國22縣市中除連江縣之外,標準化死亡率最低的縣市。
2019年起我國死因統計改依「2016 年版ICD-10 死因選取準則」,而台北市在此分類基準下,十大主要死因死亡人數占總死亡人數的7成8,其中包括慢性疾病7項(占63.0%),而惡性腫瘤(占29.5%)仍居首位,其餘依序為心臟疾病(占15.5%);肺炎(占11.0%);腦血管疾病(占6.4%);糖尿病(占4.0%);腎炎、腎病症候群及腎病變(占2.9%);慢性下呼吸道疾病(占2.8%);事故傷害(占2.1%);敗血症(占1.9%);高血壓性疾病(占1.9%)。若與「2016 年版ICD-10 死因選取準則」之2018年死因統計比較,其排名順位完全與2018年相同。
2019年台北市十大主要死因標準化死亡率較上年增加者計2項,分別為肺炎(增14.2%)、心臟疾病(高血壓性疾病除外)(增0.4%);而減少者有8項,為高血壓性疾病(減19.6%)、慢性下呼吸道疾病(減12.9%)、事故傷害(減8.8%)、腎炎、腎病症候群及腎病變(減7.7%)、腦血管疾病(減7.6%)、敗血症(減6.6%)、糖尿病(減2.1%)及惡性腫瘤(減2.0%)。
依性別觀察,死亡人數、死亡率與標準化死亡率結果呈現男高於女,分別是女性的1.3倍、1.4倍與1.6倍。2019年兩性死因前五名皆為惡性腫瘤、心臟疾病、肺炎、腦血管疾病及糖尿病,若與上年相較,男性十大死因部分以糖尿病及自殺皆上升1名,分別為第5名及第9名,而慢性下呼吸道疾病與敗血症皆退後1名,分別為第6名及第10名,其餘與上年相同;女性死因部分,僅血管性及未明示之癡呆症上升3名為第9名,事故傷害則下滑1名為第10名,其餘與上年相同。男、女性標準化死亡率分別較上年減2.2%及減2.6%,其中增幅最顯著分別為男性肺炎增16.3%,女性肺炎增11.8%,而減幅最大為男性慢性下呼吸道疾病減16.4%,女性高血壓性疾病減21.7%。
依年齡層觀察,2019年台北市15~24歲青少年死因前三名分別為自殺(占35.4%)、事故傷害(占26.6%)及惡性腫瘤(占6.3%);25~44歲壯年則以惡性腫瘤(占32.7%)為首、自殺(占16.5%)及心臟疾病(占10.6%)次之;45~64歲中年仍以惡性腫瘤(占46.8%)居首、心臟疾病(占12.8%)及腦血管疾病(占5.5%)次之;65歲以上老年則以惡性腫瘤(占26.0%)、心臟疾病(占16.4%)及肺炎(占13.2%)分列前三名。
2019年台北市民因自殺死亡人數為339人,較上年減2.9%(或減10人),其死亡人數依年齡層分以45~64歲最多占38.1%,65歲以上次之占27.1%。2019年自殺死亡率為每十萬人口12.8人,相較上年減2.2%,為全國自殺死亡率,除金門縣(10.7人)與連江縣(7.6人)外之最低縣市。
2019年台北市民癌症死亡人數為5,326人,較上年增30人,平均每日死於癌症人數約有14.6位市民;死亡率為每十萬人口200.5人,死亡者平均年齡為71.6歲;若經標準化後之死亡率為每十萬人口99.5人,較上年減2.0%,但低於全國標準化死亡率121.3人,在全國22縣市中除連江縣(76.6人)之外,為標準化死亡率的最低縣市。
十大癌症死因仍以氣管、支氣管和肺癌居首,其次依序為2.女性乳房癌、3.結腸、直腸和肛門癌、4.肝和肝內膽管癌、5.前列腺(攝護腺)癌、6.胰臟癌、7.胃癌、8.口腔癌、9.非何杰金氏淋巴瘤、10.卵巢癌;與上年相較,僅女性乳房癌前進2名,為第2名,而結腸、直腸和肛門癌與肝和肝內膽管癌分別退後1名,為第3名與第4名。其中十大癌症死因標準化死亡率較上年增加者有4項,增幅較多者為女性乳房癌(增10.6%)、非何杰金氏淋巴瘤(增8.2%);減少者有6項,減幅較多者為肝和肝內膽管癌(減6.1%)、氣管、支氣管和肺癌(減5.8%)。
依性別觀察,2019年台北市男性十大癌症死因,以胃癌與白血病上升1名,分別為第4名與第10名,而口腔癌退後1名,為第5名,其餘死因及順位與上年相同;而男性標準化死亡率較上年減2.8%,其中以胰臟癌減幅9.7%最顯著,而增幅則以白血病5.8%最多。2019年女性十大癌症死因排名變化,以非何杰金氏淋巴瘤與子宮體癌上升2名,分別為第7名與第9名,而卵巢癌退後1名為第8名,其餘死因順位與上年相同;而女性標準化死亡率較上年減0.8%,其中以胃癌減幅18.4%最顯著,增幅以非何杰金氏淋巴瘤增36.3%最多。
台北市政府衛生局呼籲,癌症已分別蟬聯38年國人死因第1名與48年台北市十大死因之首,落實健康飲食、規律運動、體重控制、遠離菸檳的健康生活型態,可預防癌症的發生。為了照護女性市民健康,自2018年6月1日起提供設籍台北市30歲以下有性生活史之女性市民,每年1次免費子宮頸抹片檢查服務,並同時提供篩檢疑似陽性個案追蹤及轉介服務,相關資訊請至台北市衛生局網站查詢。